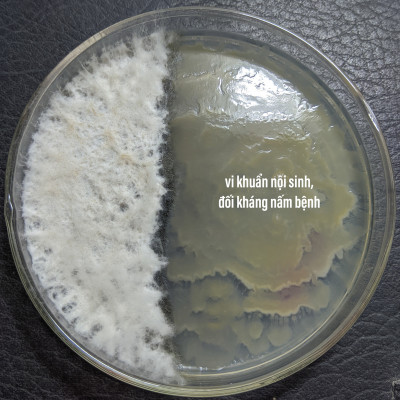

Có hiệu năng vượt trội và sự khác biệt hoàn toàn so với các loại thuốc trừ bệnh thông thường. Chế phẩm vi sinh trừ bệnh cây trồng này là sự tổng hợp của rất nhiều các chủng vi sinh vật và nấm khuẩn có lợi. Chúng có khả năng ức chế, xua đuổi và ngăn chặn sự xâm hại, phát triển của nhiều loại nấm, khuẩn gây bệnh trên cây trồng
Dòng Chế phẩm vi sinh Trừ Bệnh cây trồng này là đề tài nghiên cứu của Trung Tâm Công Nghệ Sinh Học Lục Diệp. Được sản xuất theo công nghệ lên men vi sinh hiện đại. Rất phù hợp cho canh tác Nông nghiệp theo hướng hữu cơ bền vững và hiệu quả
Chế phẩm vi sinh trừ bệnh cây trồng bao gồm các chủng vi sinh vật và nấm khuẩn có lợi như: Bacillus sp, Pseudomonas sp, Trichoderma sp 109CFU/g..
Trong chế phẩm Vi sinh Trừ Bệnh cây trồng này có chứa hàng tỷ các chủng vi sinh vật và nấm đối kháng có lợi. Chúng có khả năng thẩm thấu vào bên trong tế bào, phân bổ kháng sinh và bổ sung dinh dưỡng cho thân, cành, lá, rễ… Chúng cạnh trạnh thức ăn, đồng thời gây ức chế, ngăn chặn và tiêu diệt các nấm, khuẩn gây bệnh trên cây trồng.
Hiệu quả của Chế phẩm Vi sinh Trừ Bệnh cho cây trồng vượt trội hơn hẳn so với các loại thuốc sinh học thông thường. 100% sạch và an toàn. Không bị nhờn thuốc và gây hại như khi sử dụng thuốc hóa học.
Họat hóa: Ngâm Vi sinh Trừ Bệnh cho cây trồng bằng nước sạch trong khoảng 10-18h
(Có thể thêm mật rỉ đường và sục khí bằng máy trong 1 ngày để hoạt hóa vi sinh vật nhanh hơn)
– Phun qua lá: 1 gói pha 50-200 lit nước. Lọc lấy nước rồi phun đều ướt lá. Phun định kỳ 7 ngày/lần
– Tưới gốc: 200g/400lit nước. Tưới sát góc, xung quanh gốc
– Phun lúc mát trời, buổi tối hoặc sau khi mưa
– Nếu vườn đang bị dịch hại nặng dùng nồng độ 10g/lit nhiều lần. Không lo quá liều, quá lượng.
– Có thể pha chung với phân bón lá hoặc thuốc sinh học
– Không được pha chung với thuốc hóa học
– Ngâm nước 2-24 giờ. Bổ sung nước rửa chén theo tỉ lệ 200ml/200lit nước trước khi phun tưới, để tăng độ bám dính
– Không nên để thuốc quá 48 giờ. Nếu quá 48 giờ cần bổ sung dịch EM thứ cấp đến 10% (ngâm trong 10 lít nước thì bổ sung 1lit dịch EM thứ cấp)
– Sử dụng trước mùa sâu rầy nở hoặc mới phát hiện là cách phòng tốt nhất.
– Hiệu quả phòng trừ cao nhất sau 4-7 ngày.
– Thời gian cách ly: 0 ngày
BioThrive – Kích hoa lan nở sai, đậm màu, lâu tàn Phân bón kích hoa lan BioThrive nguồn gốc 100% hữu cơ, giàu Potassium Humate, Fulvic Acid, Ca và Bo thúc đẩy sự phát triển
Phân bón hữu cơ kích hoa giấy Docneem PHÂN BÓN DUY NHẤT TRÊN THỊ TRƯỜNG - Giúp hoa giấy lặp hoa nhanh gấp 2 lần các dạng phân bón thông thường - Công thức chuyên
BioGrow – Phân bón Siêu kích kie lan, thân mầm lá - chuyên biệt hoa lan Phân bón kích kie lan BioGrow là loại phân bón 100% hữu cơ vi sinh, giàu Potassium Humate cùng
PHÂN BÓN HỮU CƠ ĐẠM CÁ MỸ DOCNEEM: Fish Emulsion (phân bón hữu cơ đạm cá mỹ Docneem) là chế phẩm hữu cơ bón lá tinh khiết đậm đặc, được chiếc xuất từ cá Mòi
[Phân bón lá] Magie Kẽm Áo giáp kẽm (chai 500ml) - siêu xanh lá - dày lá - Quang hợp mạnh - tăng đậu trái - trái xanh - gai cứng - mang màu xanh
Công dụng Nano Bạc DOCNEEM: Phòng và điều trị hiệu quảcác loại nấm bệnh, vi khuẩn thường gặp trên hoa hồng gây đốm đen, nấm lá, phấn trắng, vàng lá, bạc lá,.. bệnh u sùi
- Phân bón lá sinh học Lephon - ETHEPHON giúp chín trái đồng loạt - Công dụng: Chế phẩm Ethephon có tác dụng giúp cây ăn trái (đã hái trái) chín nhanh, đều, màu sắc
PHÂN BÓN LÁ ĐẦU TRÂU MK 701 Phun khi Lan đã thành thục đến khi ra nụKÍCH THÍCH RA HOA * Thành phần: N: 10 %, P2O5: 30 %, K2O: 20 %, CaO: 0.05 %,
Đất trồng cây hữu cơ Soilmix, giá thể sạch trồng sen đá, hoa hồng, cây cảnh, chứa phân bón vi sinh, trichoderma, perlite Thông tin sản phẩm: Đất trồng cây Soilmix là hỗn hợp đất
- Chất điều hòa sinh trưởng KINAFON 2.5 PA hũ 450g - Công dụng: KINAFON 2.5 - Kích thích mủ cho cây cao su tăng sản lượng từ 30 - 35% cho cây từ 7 năm tuổi, giúp cây phục hồi nhanh chóng sau
PHÂN BÓN HỮU CƠ DOCNEEM SIÊU KÍCH RỄ - sự kết hợp 3 trong 1, chuyên cho hoa hồng, hoa lan, cây cảnh Thương hiệu Docneem - Bảo hộ tại Cục sở hữu trí tuệ
Thông tin sản phẩm phân trùn quế nguyên chất MONROVIA Công dụng phân trùn quế nguyên chất MONROVIA Phân trùn quế MONROVIA (hay gọi là phân giun quế) chứa khoáng chất thiết yếu giúp
THÀNH PHẦN PHÂN BÓN CHO HOA LAN DOCNEEM Mùn, mật mía, bột cá, tôm lên men, phân gà khô, phân dê khô, phân bò, phân trùn quế bổ sung bổ sung đầy đủ nguyên tố
GIÁ SỈ SIÊU LỢI: Giá chỉ còn 14k Số lượng: 200 viên Giá chỉ còn 16k Số lượng: 100 viên Xơ dừa cục Greenhome, viên 500gr, sơ dừa nén, nở gấp 5 lần, kích thích rễ, thoát nước tốt giá thể kiểng lá, phong lan ĐẶC ĐIỂM NỔI BẬT: - Xơ dừa cục/xơ dừa viên rất hữu hiệu giúp cây trồng chậu tránh ứ đọng nước gây úng - Xơ dừa cục giúp rễ bám chặt, thoáng đất, hấp thu phân bón dễ dàng- - Size 1-2cm thích hợp cho cây và chậu nhỏ, tiện cho cá nhân sử dụng - Xơ dừa già, không có chất chát, an toàn và tốt cho cây - Dùng cho tất cả các loại cây trồng: kiểng lá cao cấp, lan đột biến, bonsai, cây cảnh, trồng rau sạch... Xơ dừa cục viên rất hữu hiệu giúp cây trồng chậu tránh ứ đọng nước gây úng Xơ dừa cục giúp rễ bám chặt, thoáng đất, hấp thu phân bón dễ dàng- Size 1-2cm thích hợp cho cây và chậu nhỏ, tiện cho cá nhân sử dụng MÔ TẢ SẢN PHẨM: - Sau khi ngâm xả, dừa được chuyển qua quá trình sấy giảm ẩm để tiện cho quá trình vận chuyển và bảo quản lâu dài. - Viên 0.5kg ngâm nước nở ra 3-4kg. Xơ dừa già, không có chất chát, an toàn và tốt cho cây Xơ dừa cục dùng cho tất cả các loại cây trồng: kiểng lá cao cấp, lan đột biến, bonsai, cây cảnh, trồng rau sạch... Xơ dừa cục sau khi ngâm xả, dừa được chuyển qua quá trình sấy giảm ẩm để tiện cho quá trình vận chuyển và bảo quản lâu dài. Hướng dẫn sử dụng: - Ngâm vào nước 1-2 phút để dừa hút nước sau đó trộn sử dụng được ngay (do đã được xử lý ngâm trước đó nên dừa đã có độ ẩm cơ bản) - Lót đáy chậu nếu muốn tăng khả năng thoát nước - Trộn với giá thể khác (perlite, pumice, peatmoss,..) để trồng cây hoặc sử dụng hoàn toàn dừa cục để trồng - Rải mặt chậu giữ ẩm
Phân bón vi lượng Champion Trung vi lượng CHELATE (gói 250gr) - xanh lá, dày lá, quang hợp mạnh - chống rụng hoa - rụng trái non - to trái - chắc trái - lên
Bộ sản phẩm giúp LÚA ĐÓN ĐÒNG hiệu quả và tiết kiệm chi phí từ NANO TECH Đón đòng là một trong những giai đoạn quan trọng của lúa, quyết định năng suất cuối
Bộ sản phẩm giúp LÚA TRỔ ĐỀU, CHỐNG LẸP XẸP hiệu quả và tiết kiệm chi phí của NANO TECH Giai đoạn trước trổ là một trong những giai đoạn quan trọng của lúa, quyết
Bộ sản phẩm TRỊ NẤM, DIỆT KHUẨN cho lúa hiệu quả và tiết kiệm chi phí từ NANO TECH Nấm và Vi Khuẩn là hai trong nhiều tác nhân gây bệnh cho lúa, làm giảm
Máy Làm Sữa Hạt Ngũ Cốc Đa Năng OSTMARS – Nấu Cháo, Súp, Hẹn Giờ Thông Minh, Công Suất 600W, Dung Tích 800ml Máy Làm Sữa Hạt Đa Năng OSTMARS là thiết bị gia dụng thông minh giúp bạn chế biến nhanh chóng các món ăn dinh dưỡng như sữa hạt, cháo, súp, ngũ cốc... chỉ với vài thao tác đơn giản. Với thiết kế nhỏ gọn, công nghệ hiện đại và nhiều tính năng tiện ích, sản phẩm phù hợp cho mọi gia đình – đặc biệt là người ăn chay, mẹ bỉm sữa và người lớn tuổi. TÍNH NĂNG NỔI BẬT: - Đa chức năng tiện lợi: Chế biến sữa hạt, cháo dinh dưỡng, súp, ngũ cốc, sinh tố, nước trái cây... chỉ với 1 nút bấm. - Công suất mạnh mẽ 600W: Xay nấu nhanh chóng, tiết kiệm thời gian, giữ trọn dinh dưỡng. - Dung tích 800ml lý tưởng: Phù hợp cho gia đình nhỏ, cá nhân hoặc chế biến bữa ăn nhanh cho bé yêu. - Hẹn giờ thông minh: Linh hoạt cài đặt thời gian nấu, thuận tiện cho người bận rộn. - Chất liệu cao cấp an toàn: Cối thủy tinh dày dặn, lưỡi dao inox sắc bén chống gỉ, đảm bảo vệ sinh thực phẩm. - Thiết kế nhỏ gọn, sang trọng: Phù hợp không gian bếp hiện đại, dễ vệ sinh và bảo quản. Ưu Điểm Sản Phẩm » Máy làm sữa hạt OSTMARS là một sản phẩm đa chức năng với nhiều tính năng nổi bật. Có thể kể đến một số tính năng đáng chú ý của sản phẩm như sau: » Hẹn giờ nấu lên đến 12 giờ: tính năng này cho phép người dùng ngâm sẵn nguyên liệu và hẹn giờ máy làm sữa thành phẩm. Điều này rất tiện lợi cho những người bận rộn và giúp tiết kiệm thời gian trong việc chuẩn bị sữa. » Nấu được mọi loại hạt dinh dưỡng có trên thị trường: với tính năng này, máy có thể nấu được nhiều loại hạt khác nhau, từ đậu, ngô, ngũ cốc đến điều, macca và nhiều loại hạt dinh dưỡng khác. » Chức năng vệ sinh tự động: máy làm sữa hạt OSTMARS còn được trang bị chức năng vệ sinh tự động giúp cho việc vệ sinh sau khi sử dụng trở nên dễ dàng hơn bao giờ hết. » Thành phẩm sữa có dung tích 800ml: dung tích lớn của sản phẩm đáp ứng mọi nhu cầu của gia đình, giúp cho việc sử dụng tiện lợi và không phải lo lắng về việc phải nấu nhiều lần. » Lưỡi dao 8 lưỡi xay nhuyễn mọi loại nguyên liệu: lưỡi dao được làm từ chất liệu inox 304 cứng chắc và sắc bén, với 8 lưỡi dao xay nhuyễn nguyên liệu nhanh chóng. Điều này giúp cho thành phẩm sữa thơm ngon và nhuyễn mịn hơn. - Thiết kế nhỏ gọn, tiện lợi và có sẵn hai màu tím thủy chung và trắng trong sáng, giống như một bình đựng nước nhỏ gọn. Điều này giúp cho sản phẩm gọn nhẹ, dễ dàng sử dụng và bảo quản. » Công suất 600W: sản phẩm có công suất cao giúp cho việc nấu sữa nhanh chóng và tiết kiệm thời gian. » 8 chế độ nấu tự động: máy làm sữa hạt OSTMARS có 8 chế độ nấu tự động bao gồm nấu cháo, nấu nước, trà, sinh tố, làm sữa với các loại hạt dinh dưỡng khác nhau, giúp cho việc sử dụng sản phẩm trở nên đa dạng và tiện lợi hơn. » Tính di động: sản phẩm có thể mang đi du lịch hoặc sử dụng bất cứ nơi đâu để thưởng thức một ly sữa nóng thơm ngon và bổ dưỡng chỉ trong vòng chưa đầy 30 phút. THÔNG SỐ KỸ THUẬT: - Công suất: 600W - Dung tích: 800ml -
THÙNG 24 VIÊN NÉN MỤN DỪA PHƯỚC LỘC-TIỀN GIANG, 100% MỤN DỪA TRỒNG RAU MẦM – RAU ĂN LÁ QUY TRÌNH SẢN XUẤT : Vỏ dừa ⇒ Sàng lọc mụn ⇒ Xử lí ⇒ Thành phẩm
- Cung cấp đầy đủ các chất dinh dưỡng cho cây trồng trong giai đoạn nuôi trái. - Giúp trái lớn nhanh, mẫu mã đẹp. - Cuống trái to, dẻo dai, trái bóng đẹp, nặng
- Kích ra hoa, trổ nhiều, trổ đồng loạt, chống rụng hoa và trái non, tăng tỉ lệ đậu quả, hình thành trái, chắc hạt, trổ đều, tăng năng suất. - Giúp tăng trưởng bộ
PHÂN BÓN TĂNG TRƯỞNG : GIÚP CÂY TRỒNG RA ĐỌT NON LỚN LÁ , LƠN TRÁI DÀI THÂN THÀNH PHẦN : ĐẠM : 30 % LÂN : 10% KALI : 10 %
Phân bón tăng trưởng nhanh - TAN HOÀN TOÀN NÊN RẤT THÍCH HỢP PHUN TƯỚI , TƯỚI NHỎ GIỌT TIẾT KIỆM CÔNG LÀM THÌ RẢI 5-50 G / GỐC thành phần : đạm : 30%
CÔNG THỨC ĐẶC BIỆT ĐƯỢC PHÁT TRIỂN BỞI NGHIÊN CỨU CHUYÊN SÂU GIÚP TRÁI NON PHÁT TRIỂN KÍCH THƯỚC TỐI ĐA TRONG GIAI ĐOẠN ĐẦU TRÒN TRÁI , HẠN CHẾ MÉO MÓ BÓNG VỎ THÀNH
BOKA.Orich chứa 40% Acid Fulvic là một hợp chất hữu cơ màn cây dễ dàng hấp thụ, di chuyển vào rễ, thân, lá. - Giúp kích thích hệ vi sinh vật có lợi trong đất,
Hướng dẫn sử dụng gói dưỡng hoa tươi lâu Longlife của Israel: Bước 1: Cắt vát hoa 45 độ bằng dao, cắt tỉa chân gốc hoa và cho ngay hoa vào Dinh Dưỡng Hoa Longlife để
Cảm ơn anh/chị đã lựa chọn cửa hàng vật tư nông nghiệp Khuya Khách cần mua hàng với giá ưu đãi hơn vui lòng liên hệ: 0907.25.07.97 Phân bón vi lượng AV-EUROROOT Hoàng Hải Xô
Máy Làm Sữa Hạt Ngũ Cốc Đa Năng OSTMARS – Nấu Cháo, Súp, Hẹn Giờ Thông Minh, Công Suất 600W, Dung Tích 800ml Máy Làm Sữa Hạt Đa Năng OSTMARS là thiết bị gia dụng thông minh giúp bạn chế biến nhanh chóng các món ăn dinh dưỡng như sữa hạt, cháo, súp, ngũ cốc... chỉ với vài thao tác đơn giản. Với thiết kế nhỏ gọn, công nghệ hiện đại và nhiều tính năng tiện ích, sản phẩm phù hợp cho mọi gia đình – đặc biệt là người ăn chay, mẹ bỉm sữa và người lớn tuổi. TÍNH NĂNG NỔI BẬT: - Đa chức năng tiện lợi: Chế biến sữa hạt, cháo dinh dưỡng, súp, ngũ cốc, sinh tố, nước trái cây... chỉ với 1 nút bấm. - Công suất mạnh mẽ 600W: Xay nấu nhanh chóng, tiết kiệm thời gian, giữ trọn dinh dưỡng. - Dung tích 800ml lý tưởng: Phù hợp cho gia đình nhỏ, cá nhân hoặc chế biến bữa ăn nhanh cho bé yêu. - Hẹn giờ thông minh: Linh hoạt cài đặt thời gian nấu, thuận tiện cho người bận rộn. - Chất liệu cao cấp an toàn: Cối thủy tinh dày dặn, lưỡi dao inox sắc bén chống gỉ, đảm bảo vệ sinh thực phẩm. - Thiết kế nhỏ gọn, sang trọng: Phù hợp không gian bếp hiện đại, dễ vệ sinh và bảo quản. Ưu Điểm Sản Phẩm » Máy làm sữa hạt OSTMARS là một sản phẩm đa chức năng với nhiều tính năng nổi bật. Có thể kể đến một số tính năng đáng chú ý của sản phẩm như sau: » Hẹn giờ nấu lên đến 12 giờ: tính năng này cho phép người dùng ngâm sẵn nguyên liệu và hẹn giờ máy làm sữa thành phẩm. Điều này rất tiện lợi cho những người bận rộn và giúp tiết kiệm thời gian trong việc chuẩn bị sữa. » Nấu được mọi loại hạt dinh dưỡng có trên thị trường: với tính năng này, máy có thể nấu được nhiều loại hạt khác nhau, từ đậu, ngô, ngũ cốc đến điều, macca và nhiều loại hạt dinh dưỡng khác. » Chức năng vệ sinh tự động: máy làm sữa hạt OSTMARS còn được trang bị chức năng vệ sinh tự động giúp cho việc vệ sinh sau khi sử dụng trở nên dễ dàng hơn bao giờ hết. » Thành phẩm sữa có dung tích 800ml: dung tích lớn của sản phẩm đáp ứng mọi nhu cầu của gia đình, giúp cho việc sử dụng tiện lợi và không phải lo lắng về việc phải nấu nhiều lần. » Lưỡi dao 8 lưỡi xay nhuyễn mọi loại nguyên liệu: lưỡi dao được làm từ chất liệu inox 304 cứng chắc và sắc bén, với 8 lưỡi dao xay nhuyễn nguyên liệu nhanh chóng. Điều này giúp cho thành phẩm sữa thơm ngon và nhuyễn mịn hơn. - Thiết kế nhỏ gọn, tiện lợi và có sẵn hai màu tím thủy chung và trắng trong sáng, giống như một bình đựng nước nhỏ gọn. Điều này giúp cho sản phẩm gọn nhẹ, dễ dàng sử dụng và bảo quản. » Công suất 600W: sản phẩm có công suất cao giúp cho việc nấu sữa nhanh chóng và tiết kiệm thời gian. » 8 chế độ nấu tự động: máy làm sữa hạt OSTMARS có 8 chế độ nấu tự động bao gồm nấu cháo, nấu nước, trà, sinh tố, làm sữa với các loại hạt dinh dưỡng khác nhau, giúp cho việc sử dụng sản phẩm trở nên đa dạng và tiện lợi hơn. » Tính di động: sản phẩm có thể mang đi du lịch hoặc sử dụng bất cứ nơi đâu để thưởng thức một ly sữa nóng thơm ngon và bổ dưỡng chỉ trong vòng chưa đầy 30 phút. THÔNG SỐ KỸ THUẬT: - Công suất: 600W - Dung tích: 800ml -
- Dưỡng trái non nhanh lớn, tròn đều, hạn chế hiện tượng méo trái, sượng trái. - Giúp cải thiện kích thước và hình dạng trái. - Giúp tăng cường sức khỏe cây trồng, cây
BỘT KÍCH RỄ ISRAEL DÀNH CHO CÂY THÂN GỖ – HORMORIL T6 – Nhập khẩu: Israel – Chức năng: dùng kích thích ra rễ, giúp rễ cây phát triển nhanh và an toàn 90%. Đặc
Bộ sản phẩm DIỆT KHUẨN VÀ TRỊ ĐẠO ÔN cho lúa hiệu quả và tiết kiệm chi phí từ NANO TECH Vi Khuẩn và Đạo Ôn là hai tác nhân chủ yếu làm giảm
Combo bộ phân bón PMP trồng cà chua bạch tuộc - Phân cải tạo đất Fermic - Super Probio - Soymic V – Đạm Cá - Bã Mía THÔNG TIN SẢN PHẨM - COMBO
Combo toàn diện trồng rau sạch PMP phân hữu cơ vi sinh trồng rau sạch tại nhà, sân thượng THÔNG TIN SẢN PHẨM - COMBO GỒM: + Phân cải tạo đất Fermic 1Kg +
Amino Úc Eco-aminogro (Yellow Bee) - Eco-aminogro (Úc) sản phẩm đạt chứng nhận Hữu cơ Úc, được sử dụng rộng rãi tại Úc. *Thành phần định lượng: - Đạm tổng số (Nts): 2,5%; Lân hữu
CHẾ PHẨM EM GỐC DẠNG BỘT ⇒ Men vi sinh cao cấp với hàng tỷ vi sinh vật có lợi ⇒ Sản xuất ra EM thứ cấp: EM2, EM5, EM Tỏi, EM thảo mộc, EM
2. Phân bón lá vi lượng Codamix *Thành phần định lượng: - Fe: 33.200 ppm, Mn: 17.700 ppm, Cu: 1.200 ppm, Mo: 1.000 ppm, B: 2.600 ppm * Đối tượng sử dụng: - Cây ăn
Máy Xay Hạt Khô Mini Công Suất 300W – Nghiền Mịn Ngũ Cốc, Gia Vị, Tiện Lợi Cho Mọi Nhà Bạn đang tìm một thiết bị xay hạt nhỏ gọn, mạnh mẽ và tiện lợi để sử dụng trong căn bếp gia đình? Máy xay hạt khô mini 300W chính là lựa chọn hoàn hảo giúp bạn nghiền mịn các loại ngũ cốc, gia vị, đậu, tiêu, hạt khô… chỉ trong vài giây. Với công suất mạnh mẽ, thiết kế inox chắc chắn và thao tác đơn giản, sản phẩm phù hợp cho mọi gia đình hiện đại. Đặc điểm nổi bật: - Công suất 300W mạnh mẽ – Xay nhuyễn hạt khô nhanh chóng, tiết kiệm thời gian. - Lưỡi dao thép không gỉ sắc bén – Đảm bảo độ bền và độ mịn cao khi xay. - Xay đa dạng nguyên liệu: gạo, đậu nành, mè, hạt chia, tiêu, hạt điều, gia vị khô… - Dễ dàng vệ sinh, tháo lắp tiện lợi, đảm bảo vệ sinh an toàn thực phẩm. - Kích thước nhỏ gọn – Dễ bảo quản, không chiếm nhiều diện tích bếp. Lý tưởng cho: - Các bà nội trợ cần xay bột mịn làm bánh, nấu cháo, pha ngũ cốc cho bé. - Người ăn uống lành mạnh muốn xay hạt tươi tại nhà thay vì mua sẵn ngoài hàng. - Gia đình cần thiết bị tiện lợi, dễ dùng, tiết kiệm chi phí xay xát ngoài tiệm. #MáyXayHạtMini300W #XayNgũCốcGiaVị #MáyXayĐồKhôĐaNăng #MáyXayGiaĐình #ThiếtBịBếpTiệnLợi Sản phẩm này là tài sản cá nhân được
Thành phần, hàm lượng dinh dưỡng 1 Chất hữu cơ 28 % 2 pHH2O 5 3 Tỷ lệ C/N 12 4 Độ ẩm 30. % Sản phẩm này là tài sản cá nhân được bán
MÔ TẢ SẢN PHẨM Combo 2 Túi Dầu Neem Oil Hữu Cơ PMP Nguyên Chất Loại Bỏ Rệp, Nhện Đỏ, Nấm, Sâu Bệnh Cho Hoa Hồng, Rau THÔNG TIN SẢN PHẨM -
Combo Green Neem Hữu Cơ, Chế Phẩm Vi Sinh Biomic & Giấm Gỗ Sinh Học APY PMP Bảo Vệ Toàn Diện Hoa Hồng, Rau, Cây Cảnh THÔNG TIN SẢN PHẨM - COMBO GỒM: +
ƯU ĐIỂM VIÊN NÉN XƠ DỪA TRỒNG NGÓ DÂU THÔNG MINH SGS SO VỚI CÁCH LÀM TRUYỀN THỐNG: - Khi sử dụng Viên Nén Xơ Dừa Trồng Ngó Dâu Thông Minh SGS, nhà vườn trồng
Phân bón hữu cơ Nano TECH 2 1. Thành phần phân bón hữu cơ Nano TECH 2 Chất hữu cơ: 20%; Axit Fulvic: 3%; Đạm tổng số (Nts): 7%; Tỉ lệ C/N: 12;
Phân Bón Lá Cho Lúa BIO SIÊU RƯỚC ĐÒNG 250ml - Phân Bón Hữu Cơ Giúp Lúa Đòng To Bông Dài Nhiều Hạt THÔNG TIN SẢN PHẨM - Tên sản phẩm: Bio Siêu Rước Đòng
Đâm đọt cực mạnh - lá dày - xanh mướt Chống vàng lá - Cháy đầu lá do thiếu vi lượng - Bằng công nghệ kết hợp những chất phụ gia chuyên dùng cho cây
Chỉ tiêu chất lượng 1 Chất hữu cơ 35 % 2 Tỷ lệ C/N 12 3 Độ ẩm 30. % 4 pHH2O 5 Sản phẩm này là tài sản cá nhân được bán bởi Nhà
Phì trái hết cỡ - lớn trái tối đa - chống nứt trái - tẩy ghẻ lên màu trái cực đẹp - Cây ăn trái: cam, chanh, quýt, bưởi, sầu riêng, mãng cầu, Thanh Long
Phân bón tăng trưởng nhanh thành phần : đạm : 30% lân : 14 % kali : 5% Công thức đặc biệt giúp cây trồng : Lớn lá , to lá đồng thời mập lá
THÀNH PHẦN ĐẠM 20 % LÂN 20 % KALI 20% PHỤ GIA ĐẶC BIỆT ĐỦ 100 %
THÀNH PHẦN : ĐẠM 18 % LÂN 47 % PHỤ GIA ĐỦ 100 %
Chuyên dùng để phục hồi cây Chuyên dùng để lấy cơi, đọt Chuyên dùng để kéo đọt . Tăng cường tăng trưởng, dài thân, lớn trái
***Eco Seaweed (Úc) - Eco Seaweed (Úc) 100% chiết xuất từ Tảo nâu Ascophyllum nosodum. *Thành phần định lượng: - Chất hữu cơ: 45%; Kali hữu hiệu (K2Ohh): 10%; pHH2O: 5; Độ ẩm: 10%; Đạm
4. Phân bón lá Codafol K *Thành phần định lượng: - K2O: 24 % w/w * Đối tượng sử dụng: - Cây ăn trái: sầu riêng, thanh long, cam, quýt, chôm chôm, sapoche, xoài, nhãn…
BÍ QUYẾT TRỒNG CÂY HIỆU QUẢ THEO HƯỚNG SINH HỌC BỀN VỮNG > Rễ chắc, cành khỏe, bung đọt mạnh, ra hoa đậu trái nhiều > Chống rụng hoa, rụng trái sinh lý > Ứ
Nấm đối kháng trichoderma TRIBAC Dòng Nấm đối kháng trichoderma, bacillus cực mạnh. Khỏi lo tuyến trùng, nấm bệnh. Ủ phân hoai mục nhanh và hiệu quả ! Chế phẩm vi sinh TRIBAC là dòng chế
Chế phẩm sinh học EM (Chế phẩm EM gốc) Giải pháp toàn diện cho chăn nuôi, trồng trọt và nuôi trồng thủy sản ! Chế phẩm sinh học EM (Effective Microorganismas) hay còn gọi là Vi sinh vật
Chế phẩm sinh học EM gốc Men vi sinh chuẩn gốc của Trường ĐH Nông Nghiệp 1 Hà Nội Là các chủng vi sinh vật hữu hiệu được phân lập từ tự nhiên hoàn toàn không độc
Thành phần, hàm lượng dinh dưỡng 1 Đạm tổng số (Nts) 30 % 2 Lân hữu hiệu (P2O5hh) 10 % 3 Kali hữu hiệu (K2Ohh) 10 % Sản phẩm này là tài sản cá nhân
Máy Xay Hạt Khô Mini Công Suất 300W – Nghiền Mịn Ngũ Cốc, Gia Vị, Tiện Lợi Cho Mọi Nhà Bạn đang tìm một thiết bị xay hạt nhỏ gọn, mạnh mẽ và tiện lợi để sử dụng trong căn bếp gia đình? Máy xay hạt khô mini 300W chính là lựa chọn hoàn hảo giúp bạn nghiền mịn các loại ngũ cốc, gia vị, đậu, tiêu, hạt khô… chỉ trong vài giây. Với công suất mạnh mẽ, thiết kế inox chắc chắn và thao tác đơn giản, sản phẩm phù hợp cho mọi gia đình hiện đại. Đặc điểm nổi bật: - Công suất 300W mạnh mẽ – Xay nhuyễn hạt khô nhanh chóng, tiết kiệm thời gian. - Lưỡi dao thép không gỉ sắc bén – Đảm bảo độ bền và độ mịn cao khi xay. - Xay đa dạng nguyên liệu: gạo, đậu nành, mè, hạt chia, tiêu, hạt điều, gia vị khô… - Dễ dàng vệ sinh, tháo lắp tiện lợi, đảm bảo vệ sinh an toàn thực phẩm. - Kích thước nhỏ gọn – Dễ bảo quản, không chiếm nhiều diện tích bếp. Lý tưởng cho: - Các bà nội trợ cần xay bột mịn làm bánh, nấu cháo, pha ngũ cốc cho bé. - Người ăn uống lành mạnh muốn xay hạt tươi tại nhà thay vì mua sẵn ngoài hàng. - Gia đình cần thiết bị tiện lợi, dễ dùng, tiết kiệm chi phí xay xát ngoài tiệm. #MáyXayHạtMini300W #XayNgũCốcGiaVị #MáyXayĐồKhôĐaNăng #MáyXayGiaĐình #ThiếtBịBếpTiệnLợi Sản phẩm này là tài sản cá nhân được
CHẾ PHẨM XỬ LÝ HOA CÚC LƯỚI TOG GALILEO ISRAEL PHÙ HỢP NHÀ VƯỜN TRỒNG HOA VÀ CHỢ SỈ HOA - Nhập khẩu: ISRAEL - Thành phần chế phẩm TOG GALILEO: Chất kháng khuẩn, Chất
 Mua tại Shopee
Mua tại Shopee Mua tại Tiki
Mua tại Tiki Mua tại Lazada
Mua tại Lazada Mua tại Tiktok
Mua tại Tiktok

Mua tại Shopee
Mua tại Shopee Mua tại Tiki
Mua tại Tiki Mua tại Lazada
Mua tại Lazada Mua tại Tiktok
Mua tại Tiktok
 Phân bón kích hoa chuyên biệt cho hoa lan BIOTHRIVE giúp phong lan nở sai hoa hơn, lâu tàn, chuẩn form và đậm màu, hàng chính hãng thương hiệu Docneem
Phân bón kích hoa chuyên biệt cho hoa lan BIOTHRIVE giúp phong lan nở sai hoa hơn, lâu tàn, chuẩn form và đậm màu, hàng chính hãng thương hiệu Docneem  Phân bón hoa giấy DOCNEEM, kích bông giấy ngũ sắc, cẩm thạch, thái, mỹ sai hoa, lặp hoa nhanh, nở đồng loạt, chai 1 lít
Phân bón hoa giấy DOCNEEM, kích bông giấy ngũ sắc, cẩm thạch, thái, mỹ sai hoa, lặp hoa nhanh, nở đồng loạt, chai 1 lít  Phân bón kích Kei, thân mầm lá cho hoa Lan BioGrow, chuyên biệt cho phong lan, giúp dưỡng thân mầm lá xanh tươi, kích kie phi điệp, giúp mầm ra nhanh, nuôi kie mập khoẻ, hàng chính hãng, thương hiệu Docneem
Phân bón kích Kei, thân mầm lá cho hoa Lan BioGrow, chuyên biệt cho phong lan, giúp dưỡng thân mầm lá xanh tươi, kích kie phi điệp, giúp mầm ra nhanh, nuôi kie mập khoẻ, hàng chính hãng, thương hiệu Docneem  Phân đạm cá Docneem, phân cá Fish Emulsion (1 lít) hữu cơ cho hoa hồng, rau sạch, hoa, cây kiểng trong nhà ngoài trời
Phân đạm cá Docneem, phân cá Fish Emulsion (1 lít) hữu cơ cho hoa hồng, rau sạch, hoa, cây kiểng trong nhà ngoài trời  Phân bón lá Magie Kẽm Áo giáp kẽm (chai 500ml) - siêu xanh lá - dày lá - Quang hợp mạnh - tăng đậu trái - trái xanh - gai cứng - mang màu xanh đến cho cây trồng
Phân bón lá Magie Kẽm Áo giáp kẽm (chai 500ml) - siêu xanh lá - dày lá - Quang hợp mạnh - tăng đậu trái - trái xanh - gai cứng - mang màu xanh đến cho cây trồng  Nano Bạc DOCNEEM nguyên chất Diệt sạch nấm bệnh, vi khuẩn hoa hồng, phong lan chai 100ml
Nano Bạc DOCNEEM nguyên chất Diệt sạch nấm bệnh, vi khuẩn hoa hồng, phong lan chai 100ml  Phân bón sinh học Lephon - ETHEPHON giúp chín trái đồng loạt và đẹp - chai 500ml
Phân bón sinh học Lephon - ETHEPHON giúp chín trái đồng loạt và đẹp - chai 500ml  Combo phân bón kích thích ra hoa Đầu Trâu - MK Amica + MK 701
Combo phân bón kích thích ra hoa Đầu Trâu - MK Amica + MK 701  Đất trồng cây SOILMIX cho hoa hồng, cây cảnh, sen đá, rau sạch hữu cơ, bổ sung phân bón vi sinh, trichoderma, đá perlite
Đất trồng cây SOILMIX cho hoa hồng, cây cảnh, sen đá, rau sạch hữu cơ, bổ sung phân bón vi sinh, trichoderma, đá perlite  Thuốc điều hòa sinh trưởng KINAFON 2.5 PA giúp kích thích tăng sản lượng mủ cây cao su
Thuốc điều hòa sinh trưởng KINAFON 2.5 PA giúp kích thích tăng sản lượng mủ cây cao su  Phân bón hữu cơ rong biển DOCNEEM túi 1kg, kết hợp neem cake kích rễ mầm lá, cho Hoa hồng, phong lan, cây cảnh, rau sạch
Phân bón hữu cơ rong biển DOCNEEM túi 1kg, kết hợp neem cake kích rễ mầm lá, cho Hoa hồng, phong lan, cây cảnh, rau sạch  Phân trùn quế nguyên chất MONROVIA, viên nén tan chậm hữu cơ bón cho hoa hồng, lan, cây cảnh, rau củ quả
Phân trùn quế nguyên chất MONROVIA, viên nén tan chậm hữu cơ bón cho hoa hồng, lan, cây cảnh, rau củ quả  Phân bón cho hoa lan DOCNEEM tan chậm, viên nén dinh dưỡng hữu cơ vi sinh ben 01 cho hoa lan, túi 0.5 kg, chính hãng
Phân bón cho hoa lan DOCNEEM tan chậm, viên nén dinh dưỡng hữu cơ vi sinh ben 01 cho hoa lan, túi 0.5 kg, chính hãng  Xơ Dừa Cục Greenhome, Viên 500gr, Sơ Dừa Nén, Nở Gấp 5 Lần, Kích Thích Rễ, Thoát Nước Tốt Giá Thể Kiểng Lá, Phong Lan
Xơ Dừa Cục Greenhome, Viên 500gr, Sơ Dừa Nén, Nở Gấp 5 Lần, Kích Thích Rễ, Thoát Nước Tốt Giá Thể Kiểng Lá, Phong Lan  Phân bón vi lượng Champion Trung vi lượng CHELATE (gói 250gr) - xanh lá, dày lá, quang hợp mạnh - chống rụng hoa - rụng trái non - to trái - chắc trái - lên màu đẹp
Phân bón vi lượng Champion Trung vi lượng CHELATE (gói 250gr) - xanh lá, dày lá, quang hợp mạnh - chống rụng hoa - rụng trái non - to trái - chắc trái - lên màu đẹp  Bộ sản phẩm giúp LÚA ĐÓN ĐÒNG hiệu quả, tiết kiệm chi phí
Bộ sản phẩm giúp LÚA ĐÓN ĐÒNG hiệu quả, tiết kiệm chi phí  Bộ sản phẩm giúp LÚA TRỔ ĐỀU, CHỐNG LẸP XẸP hiệu quả và tiết kiệm chi phí
Bộ sản phẩm giúp LÚA TRỔ ĐỀU, CHỐNG LẸP XẸP hiệu quả và tiết kiệm chi phí  Bộ sản phẩm TRỊ NẤM, DIỆT KHUẨN cho lúa hiệu quả và tiết kiệm chi phí
Bộ sản phẩm TRỊ NẤM, DIỆT KHUẨN cho lúa hiệu quả và tiết kiệm chi phí  Máiy Làm Sữa Hạt Ngũ Cốc Đa Năng OSTMARS – Nấu Cháo, Súp, Sữa Hạt Đều Ngon Loại Xịn, đèn ốp trần
Máiy Làm Sữa Hạt Ngũ Cốc Đa Năng OSTMARS – Nấu Cháo, Súp, Sữa Hạt Đều Ngon Loại Xịn, đèn ốp trần  THÙNG 24 VIÊN NÉN MỤN DỪA PHƯỚC LỘC-TIỀN GIANG, 100% MỤN DỪA TRỒNG RAU MẦM – RAU ĂN LÁ
THÙNG 24 VIÊN NÉN MỤN DỪA PHƯỚC LỘC-TIỀN GIANG, 100% MỤN DỪA TRỒNG RAU MẦM – RAU ĂN LÁ  VIF-MIX II - Phân bón Dưỡng trái can 20kg
VIF-MIX II - Phân bón Dưỡng trái can 20kg  VIFUSA-P15 - Phân bón Lân hữu cơ can 20kg
VIFUSA-P15 - Phân bón Lân hữu cơ can 20kg  XÔ 15 KG PHÂN BÓN TĂNG TRƯỞNG NPK 30-10-10 TE
XÔ 15 KG PHÂN BÓN TĂNG TRƯỞNG NPK 30-10-10 TE  PHÂN BÓN TƯỚI PHUN , TƯỚI NHỎ GIỌT, RẢI GỐC - XÔ 15KG PHÂN BÓN TĂNG TRƯỞNG NPK 30-14-5 TE , LỚN LÁ , TO LÁ, LỚN TRÁI , DÀI THÂN , MẬP THÂN , MẬP NỤ
PHÂN BÓN TƯỚI PHUN , TƯỚI NHỎ GIỌT, RẢI GỐC - XÔ 15KG PHÂN BÓN TĂNG TRƯỞNG NPK 30-14-5 TE , LỚN LÁ , TO LÁ, LỚN TRÁI , DÀI THÂN , MẬP THÂN , MẬP NỤ  XÔ PHÂN BÓN NỞ TRÁI , TĂNG KÍCH CƠ TRÁI NON TỒI ĐA , NPK 20-15-17 TE
XÔ PHÂN BÓN NỞ TRÁI , TĂNG KÍCH CƠ TRÁI NON TỒI ĐA , NPK 20-15-17 TE  BOKA.Orich - Phân bón Root gold can 20kg
BOKA.Orich - Phân bón Root gold can 20kg  Bộ 5 hộp Loại 1KG Chế phẩm xử lý hoa Longlife của Israel - Bảo quản hoa cắm bình tươi lâu và 14 ngày không thối nước
Bộ 5 hộp Loại 1KG Chế phẩm xử lý hoa Longlife của Israel - Bảo quản hoa cắm bình tươi lâu và 14 ngày không thối nước  Phân bón vi lượng AV-EUROROOT Hoàng Hải Xô Đạm Cá Hồi 20kg
Phân bón vi lượng AV-EUROROOT Hoàng Hải Xô Đạm Cá Hồi 20kg  Máiy Làm Sữa Hạt Ngũ Cốc Đa Năng OSTMARS – Nấu Cháo, Súp, Sữa Hạt Đều Ngon Loại Xịn, đèn ốp trần
Máiy Làm Sữa Hạt Ngũ Cốc Đa Năng OSTMARS – Nấu Cháo, Súp, Sữa Hạt Đều Ngon Loại Xịn, đèn ốp trần  VIF-MIX I - Phân bón Thúc trái can 20kg
VIF-MIX I - Phân bón Thúc trái can 20kg  Bột Kích Ra Rễ Israel cho cây Thân Gỗ Hormoril T6 (T with Fungicide)
Bột Kích Ra Rễ Israel cho cây Thân Gỗ Hormoril T6 (T with Fungicide)  Bộ sản phẩm DIỆT KHUẨN VÀ TRỊ ĐẠO ÔN cho lúa hiệu quả và tiết kiệm chi phí
Bộ sản phẩm DIỆT KHUẨN VÀ TRỊ ĐẠO ÔN cho lúa hiệu quả và tiết kiệm chi phí  Combo bộ phân bón hữu cơ PMP trồng cà chua bạch tuộc - Phân cải tạo đất Fermic - Super Probio - Soymic V – Đạm Cá - Bã Mía
Combo bộ phân bón hữu cơ PMP trồng cà chua bạch tuộc - Phân cải tạo đất Fermic - Super Probio - Soymic V – Đạm Cá - Bã Mía  Phân bón hữu cơ Combo phân PMP trồng rau sạch tại nhà, sân thượng
Phân bón hữu cơ Combo phân PMP trồng rau sạch tại nhà, sân thượng  Amino Úc Eco-aminogro (Yellow Bee) nhập khẩu trực tiếp chai 500ml
Amino Úc Eco-aminogro (Yellow Bee) nhập khẩu trực tiếp chai 500ml  Combo 5 gói Chế phẩm sinh học EM gốc 500g - Chứa hàng tỷ vi sinh vật có lợi - Men vi sinh ủ cá, rác bã hữu cơ làm phân bón - Xử lý mùi hôi
Combo 5 gói Chế phẩm sinh học EM gốc 500g - Chứa hàng tỷ vi sinh vật có lợi - Men vi sinh ủ cá, rác bã hữu cơ làm phân bón - Xử lý mùi hôi  Codamix- Phân bón lá vi lượng nhập khẩu trực tiếp từ Tây Ban Nha (chai 1L)
Codamix- Phân bón lá vi lượng nhập khẩu trực tiếp từ Tây Ban Nha (chai 1L)  Májy Xay Ngữ Cốc Mini 300W – Nghiền Được Gạjo,Đậu,Tiêu,Gia Vị, Ngjũ Cốc Nhanh Mịn Loại Xịn, đèn ốp trần
Májy Xay Ngữ Cốc Mini 300W – Nghiền Được Gạjo,Đậu,Tiêu,Gia Vị, Ngjũ Cốc Nhanh Mịn Loại Xịn, đèn ốp trần  Humic Organic Đạm cá Amino bao 10kg - bung đọt, phì trái, tốt cây, xanh lá
Humic Organic Đạm cá Amino bao 10kg - bung đọt, phì trái, tốt cây, xanh lá  Combo 2 Túi Dầu Neem Oil Hữu Cơ PMP Nguyên Chất Loại Bỏ Rệp, Nhện Đỏ, Nấm, Sâu Bệnh Cho Hoa Hồng, Rau Sạch Green Neem
Combo 2 Túi Dầu Neem Oil Hữu Cơ PMP Nguyên Chất Loại Bỏ Rệp, Nhện Đỏ, Nấm, Sâu Bệnh Cho Hoa Hồng, Rau Sạch Green Neem  Combo Green Neem Hữu Cơ, Chế Phẩm Vi Sinh Biomic & Giấm Gỗ Sinh Học APY PMP Bảo Vệ Toàn Diện Hoa Hồng, Rau, Cây Cảnh
Combo Green Neem Hữu Cơ, Chế Phẩm Vi Sinh Biomic & Giấm Gỗ Sinh Học APY PMP Bảo Vệ Toàn Diện Hoa Hồng, Rau, Cây Cảnh  Viên Nén Xơ Dừa Trồng Ngó Dâu Thông Minh SGS (set 100 viên) đã bao gồm phân bón hữu cơ cho cây phát triển tốt trong 30 ngày
Viên Nén Xơ Dừa Trồng Ngó Dâu Thông Minh SGS (set 100 viên) đã bao gồm phân bón hữu cơ cho cây phát triển tốt trong 30 ngày  Phân bón hữu cơ Nano Organic One TN TECH 2 giúp đòng to, bông bự, đầy hạt, nặng ký
Phân bón hữu cơ Nano Organic One TN TECH 2 giúp đòng to, bông bự, đầy hạt, nặng ký  Phân bón BIO Siêu Rước Đòng dạng nước Chai 250ml - Mập Đòng, Dài Bông
Phân bón BIO Siêu Rước Đòng dạng nước Chai 250ml - Mập Đòng, Dài Bông  Phân bón lá Siêu Vọt Đọt Chuyên sầu riêng chai 500ml - đâm đọt cực mạnh - lá dày - xanh mướt
Phân bón lá Siêu Vọt Đọt Chuyên sầu riêng chai 500ml - đâm đọt cực mạnh - lá dày - xanh mướt  Phân bón hữu cơ Cty Bio Delta Gold Humic Hữu Cơ USA (1Kg) - ra rễ, hạ phèn, giải độc hữu cơ
Phân bón hữu cơ Cty Bio Delta Gold Humic Hữu Cơ USA (1Kg) - ra rễ, hạ phèn, giải độc hữu cơ  Phân bón vi lượng Viên Sủi YMC viên 7gr - Phì trái hết cỡ - lớn trái tối đa - chống nứt trái - tẩy ghẻ lên màu trái cực đẹp
Phân bón vi lượng Viên Sủi YMC viên 7gr - Phì trái hết cỡ - lớn trái tối đa - chống nứt trái - tẩy ghẻ lên màu trái cực đẹp  XÔ PHÂN BÓN TĂNG TRƯỞNG NPK 30-14-5 TE , LỚN LÁ , TO LÁ, LỚN TRÁI , DÀI THÂN , MẬP THÂN , MẬP NỤ
XÔ PHÂN BÓN TĂNG TRƯỞNG NPK 30-14-5 TE , LỚN LÁ , TO LÁ, LỚN TRÁI , DÀI THÂN , MẬP THÂN , MẬP NỤ  XÔ 15 KG PHÂN BÓN NPK 20-20-15 TE , THÍCH HỢP TƯỚI PHUN TƯỚI NHỎ GIỌT
XÔ 15 KG PHÂN BÓN NPK 20-20-15 TE , THÍCH HỢP TƯỚI PHUN TƯỚI NHỎ GIỌT  NP 18-47-0 HÀM LƯỢNG PHÂN BÓN CAO HƠN DAP CAO CẤP
NP 18-47-0 HÀM LƯỢNG PHÂN BÓN CAO HƠN DAP CAO CẤP  BIO MONYKA
BIO MONYKA  Eco Seaweed Úc 100% từ tảo nâu (hộp 600g)
Eco Seaweed Úc 100% từ tảo nâu (hộp 600g)  Codafol K - Phân bón lá nhập khẩu trực tiếp từ Tây Ban Nha (chai 1L)
Codafol K - Phân bón lá nhập khẩu trực tiếp từ Tây Ban Nha (chai 1L)  Combo 5 chai Chế phẩm sinh học VƯỜN SINH THÁI. Phân bón sinh học NANO giúp cây trồng rễ chắc, cành khỏe, đọt mạnh, ra hoa đậu trái nhiều. Chống rụng hoa, rụng quả sinh lý
Combo 5 chai Chế phẩm sinh học VƯỜN SINH THÁI. Phân bón sinh học NANO giúp cây trồng rễ chắc, cành khỏe, đọt mạnh, ra hoa đậu trái nhiều. Chống rụng hoa, rụng quả sinh lý  Combo 5 gói Chế phẩm vi sinh Trichoderma TRIBAC. Nấm Đối Kháng cực mạnh. Ngăn chặn tuyến trùng, nấm bệnh gây vàng lá thối rễ. Ủ phân chuồng hoai mục
Combo 5 gói Chế phẩm vi sinh Trichoderma TRIBAC. Nấm Đối Kháng cực mạnh. Ngăn chặn tuyến trùng, nấm bệnh gây vàng lá thối rễ. Ủ phân chuồng hoai mục  Chế phẩm sinh học EM gốc (EM1). Men vi sinh Đại Học Nông Nghiệp 1 Hà Nội. Chứa hàng tỷ bào tử hữu hiệu. Từ 1 lít EM gốc sản xuất ra 40 lít EM thứ cấp. Can 10 lít. HSD: 2 năm
Chế phẩm sinh học EM gốc (EM1). Men vi sinh Đại Học Nông Nghiệp 1 Hà Nội. Chứa hàng tỷ bào tử hữu hiệu. Từ 1 lít EM gốc sản xuất ra 40 lít EM thứ cấp. Can 10 lít. HSD: 2 năm  Combo 2 chai Chế phẩm sinh học EM gốc (EM1). Men vi sinh Đại Học Nông Nghiệp 1 Hà Nội. Chứa hàng tỷ bào tử hữu hiệu. Từ 1 lít EM gốc sản xuất ra 40 lít EM thứ cấp. HSD: 2 năm
Combo 2 chai Chế phẩm sinh học EM gốc (EM1). Men vi sinh Đại Học Nông Nghiệp 1 Hà Nội. Chứa hàng tỷ bào tử hữu hiệu. Từ 1 lít EM gốc sản xuất ra 40 lít EM thứ cấp. HSD: 2 năm  Phân bón NPK 30-10-10 TE CCV Bao 25kg
Phân bón NPK 30-10-10 TE CCV Bao 25kg  Májy Xay Ngữ Cốc Mini 300W – Nghiền Được Gạjo,Đậu,Tiêu,Gia Vị, Ngjũ Cốc Nhanh Mịn, đèn ốp trần
Májy Xay Ngữ Cốc Mini 300W – Nghiền Được Gạjo,Đậu,Tiêu,Gia Vị, Ngjũ Cốc Nhanh Mịn, đèn ốp trần  Xử Lý Hoa Cúc Cắt Cành Bằng Chế Phẩm Tog Galileo Của Israel (Chai 1 Lít)
Xử Lý Hoa Cúc Cắt Cành Bằng Chế Phẩm Tog Galileo Của Israel (Chai 1 Lít)  Sách - Luân Xa
Sách - Luân Xa  Những Câu Hỏi Lớn - Toán Học (Tặng kèm sổ tay)
Những Câu Hỏi Lớn - Toán Học (Tặng kèm sổ tay)  Những Câu Hỏi Lớn Vật Lý
Những Câu Hỏi Lớn Vật Lý  Những Câu Hỏi Lớn - Vật Lý
Những Câu Hỏi Lớn - Vật Lý ![[Einstetin Books] Những Câu Hỏi Lớn - Vũ Trụ](/datafiles/2025-17/575f1745a0ccf9944cfb6fcabc9bcc15.png) [Einstetin Books] Những Câu Hỏi Lớn - Vũ Trụ
[Einstetin Books] Những Câu Hỏi Lớn - Vũ Trụ  Lợi Ích Sức Khoẻ Từ Dừa - Bruce Fife, N.D.; Trần Doãn Hưng dịch
Lợi Ích Sức Khoẻ Từ Dừa - Bruce Fife, N.D.; Trần Doãn Hưng dịch  Sách - Sách Của Những Bí Mật - Tập 3 - Chính Thông Book
Sách - Sách Của Những Bí Mật - Tập 3 - Chính Thông Book  Trở Thành Ứng Viên Được Săn Đón - Lynn Williams - NXB Thế Giới
Trở Thành Ứng Viên Được Săn Đón - Lynn Williams - NXB Thế Giới  Những Câu Hỏi Lớn - Vật Lý (Tặng kèm sổ tay)
Những Câu Hỏi Lớn - Vật Lý (Tặng kèm sổ tay) ![[Einstetin Books] Những Vùng Đất Trường Thọ](/datafiles/2025-17/1acbfef43b30d5a70bcd18eb5187ca38.jpg) [Einstetin Books] Những Vùng Đất Trường Thọ
[Einstetin Books] Những Vùng Đất Trường Thọ ![[Einstetin Books] Đi Tìm Sisu : Triết Lý Phần Lan Trong Hành Trình Kiếm Tìm Lòng Dũng Cảm, Sức Mạnh và Hạnh Phúc](/datafiles/2025-17/30452aea5d7114144907a90fa7456c2c.jpg) [Einstetin Books] Đi Tìm Sisu : Triết Lý Phần Lan Trong Hành Trình Kiếm Tìm Lòng Dũng Cảm, Sức Mạnh và Hạnh Phúc
[Einstetin Books] Đi Tìm Sisu : Triết Lý Phần Lan Trong Hành Trình Kiếm Tìm Lòng Dũng Cảm, Sức Mạnh và Hạnh Phúc  Sách - Tiếng Việt Ân Tình - Tập 2 - Thái Hà Books
Sách - Tiếng Việt Ân Tình - Tập 2 - Thái Hà Books  Vật Lý 10 - Tuyệt Kỹ Các Thủ Thuật Giải Nhanh Tự Luận - Trắc Nghiệm
Vật Lý 10 - Tuyệt Kỹ Các Thủ Thuật Giải Nhanh Tự Luận - Trắc Nghiệm  Combo Big 4 Bộ Đề Tự Kiểm Tra 4 Kỹ Năng Nghe - Nói - Đọc - Viết Tiếng Anh (Cơ Bản Và Nâng Cao) 6 Tập 1 + 2 (Bộ 2 Cuốn) _Mega
Combo Big 4 Bộ Đề Tự Kiểm Tra 4 Kỹ Năng Nghe - Nói - Đọc - Viết Tiếng Anh (Cơ Bản Và Nâng Cao) 6 Tập 1 + 2 (Bộ 2 Cuốn) _Mega  Không Tức Giận Bạn Đã Thắng
Không Tức Giận Bạn Đã Thắng  Thuật Hack Não
Thuật Hack Não  Làm Ra Làm, Chơi Ra Chơi (Tái bản 2021)
Làm Ra Làm, Chơi Ra Chơi (Tái bản 2021)  Sách - Làm Ra Làm, Chơi Ra Chơi (Tái Bản 2021)
Sách - Làm Ra Làm, Chơi Ra Chơi (Tái Bản 2021)  Hành Trình Tarot - Hiểu Về Quá Khứ, Tin Ở Hiện Tại, Nắm Lấy Tương Lai (Tái Bản 2022)
Hành Trình Tarot - Hiểu Về Quá Khứ, Tin Ở Hiện Tại, Nắm Lấy Tương Lai (Tái Bản 2022)  Tư Duy Logic Quyết Định Hành Vi
Tư Duy Logic Quyết Định Hành Vi